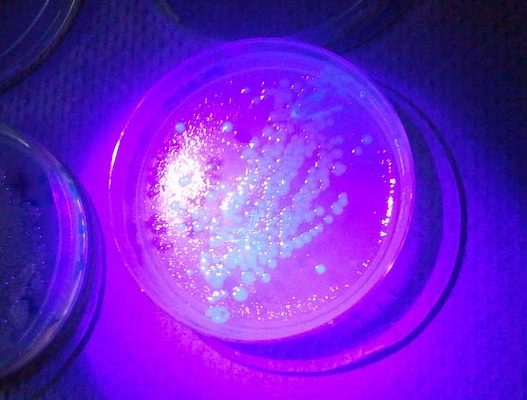

healthcare
تنصح طبيبة الأطفال الألمانية غابرييل برينكهوس الآباء بضرورة استشارة طبيب مختص، إذا ما عانى طفلهم من آلام في الظهر لمدة تزيد عن شهر، خاصة إذا ما أعاقت هذه الآلام الطفل عن متابعة الدراسة وممارسة الرياضة واللعب مع أقرانه أو منعته من النوم ليلاً.
ذكر أحد المعاهد الصحية الألمانية أن هناك زيادة مطردة في معدل صرف الأطباء الألمان للأدوية ذات المقاومة الشديدة للآلام إلى مرضاهم.
يُمكن أن يرجع السبب في ضعف التركيز وتدهور القدرة على بذل مجهود بدني خلال النهار، إلى الإصابة بشخير قوي أثناء الليل؛ حيث لا يُمكن لمَن يشخر بقوة أثناء الليل أن يحظى بقدر كاف من النوم.
يتبع الأشخاص الراغبون في إنقاص أوزانهم قاعدة تنص على ضرورة تجنب تناول الطعام في المساء؛ لأنه يؤدي إلى زيادة الوزن. غير أن خبيرة التغذية الألمانية غيزيلا أولياس أكدت خطأ هذه القاعدة الشائعة، موضحة أن توقيت تناول الطعام ليس هو العامل الحاسم في إنقاص الوزن.
يشتهر الثوم بفوائده الصحية الجمّة منذ قديم الأزل، حيث ورد ذكر الثوم كمادة علاجية في المخطوطات الفرعونية التي يرجع تاريخها إلى عام 1550 قبل الميلاد. وفي وقتنا الحاضر أثبت العلم المعاصر تأثير الثوم الوقائي الفعال ضد باقة واسعة من الأمراض التي تصيب القلب والأوعية الدموية والأسنان وغيرها من أعضاء الجسم.
قال علماء من أمريكا إنهم قطعوا خطوة أخرى على طريق تطوير أقراص تجعل الرجل عقيما أثناء الجماع وذلك على غرار أقراص منع الحمل لدى المرأة.
أكد فريق من الباحثين بمعهد كارولينسكا السويدي أن الاشخاص الذين يشتغلون في مهن تتطلب قدرا من الابداع يصابون بأمراض عقلية أكثر من عامة الناس.
قال جراحون في مركز قلب بألمانيا إنهم نجحوا ولأول مرة في زراعة دعامة ذاتية التحلل في شريان قلب مريض.
كشف استقصاء حديث أن أسعد مراحل حياة الإنسان لا تكون في الغالب في بدايته أو آخره ولا حتى في وسطه.
خضعت أكثر من 13500 فرنسية لجراحات لإزالة منزرعات ثدي معرضة للتمزق صنعتها شركة "بولي أمبلنت بروتيس" ، كانت قد أثارت مخاوف صحية في جميع أنحاء العالم في وقت سابق من العام الجاري، حسبما أظهر تقرير صدر مؤخراً.